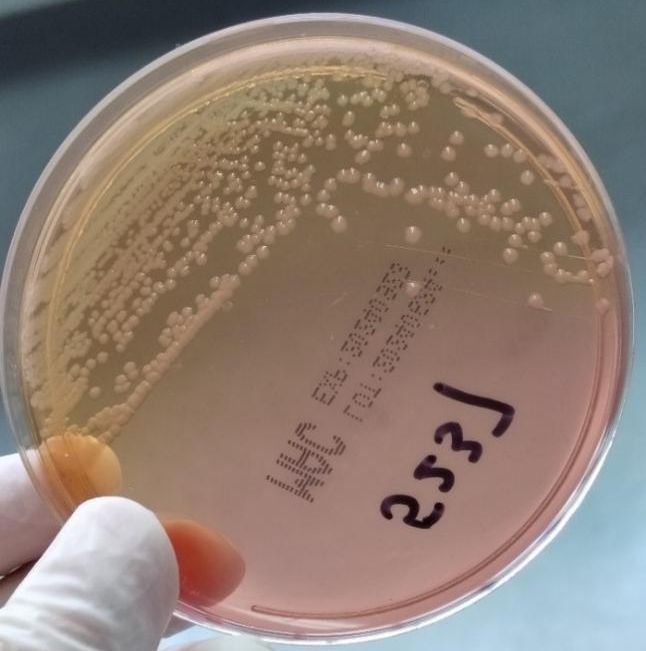
沙门氏菌疫情蔓延】

1、一疫情核心信息疫情起源与关联产品 欧美多国暴发的沙门氏菌疫情与比利时生产的巧克力产品直接相关涉事巧克力已销往全球至少113个国家和地区,包括中国英国于3月27日向世界卫生组织WHO通报了单相鼠伤寒沙门氏菌序列34型感染的聚集性病例,调查指向比利时巧克力病例统计与症状 截至4月25日,11个;此次多国暴发的巧克力相关沙门氏菌疫情已波及中国,目前无死亡报告,但需关注产品召回及预防措施具体内容如下疫情概况起源与关联产品此次疫情由比利时生产的巧克力产品引发,涉及单相鼠伤寒沙门氏菌序列34型传播范围相关巧克力已销往至少113个国家和地区,包括中国病例统计截至4月25日,11个国家报告。
2、近日,欧美多国暴发了与比利时生产的巧克力产品有关的沙门氏菌疫情这些巧克力已经销往至少113个国家和地区,其中包括中国,引发了全球范围内的关注和警惕一疫情背景与感染源 据世卫组织介绍,此次疫情与比利时生产的巧克力有关,特别是意大利费列罗集团在比利时阿尔隆工厂生产的Kinder巧克力系列产品感染源;四本周重点舆情事件德国和奥地利调查儿童沙门氏菌疫情6月6日,两国当局调查一起主要感染儿童的沙门氏菌疫情,60余名儿童患病,初步怀疑与食品相关,具体感染源正在排查中事件提醒行业需加强病原微生物防控,尤其是针对儿童食品的安全管理四川曹氏鸭脖收“最低消费燃气费”6月3日,四川自贡一;近期因欧美多国暴发与比利时生产巧克力相关的沙门氏菌疫情,问题巧克力已销往多国,我国海关针对进口巧克力有严格的通关规定及消费提醒 具体内容如下沙门氏菌相关情况定义沙门氏菌属是一大群形态生化性状及抗原构造相似的革兰氏阴性杆菌,是常见食物来源致病菌,也是世界各国常见引发细菌性食物中毒的。
3、爱尔兰2018年,爱尔兰产的婴儿奶粉怀疑被沙门氏菌污染,且生产出口的奶粉中发现死昆虫美国2018年,美国33个州爆发沙门氏菌疫情,4个月致100人感染,感染者最小才1岁,与一家乳清供应商有关,但该公司发言人拒绝公布客户名单乳清粉是常见食品原料,常用于儿童食品和婴幼儿奶粉2022年4月1日;夏天,新鲜蔬果大量上市,然而在美国,这个夏天却因生吃西红柿引发了一场中毒事件据最新统计,美国已有30个州数百人因生吃了从墨西哥进口的带有沙门氏菌的西红柿而中毒,其中48人病情严重,1人死亡这让很多人对生吃蔬果的安全性产生了疑问专家指出,并非所有蔬果都适合生吃对于某些蔬菜和水果,最好;其不分解蛋白质的特性使被污染食品外观无异常,难以通过感官察觉感染规模与后果据WHO统计,全球每年约18亿人因沙门氏菌患腹泻,298万人死亡近年欧美多国暴发的巧克力相关疫情151例病例及美国25州疫情,均凸显其严重性传统防控局限现有措施如防止污染控制繁殖加热杀菌等,无法彻底;预防欧美多国暴发的巧克力相关沙门氏菌疫情,需从选购食用及日常卫生习惯等多方面着手,以下为具体预防措施谨慎选购巧克力产品优先选择可靠品牌与产地近期购买巧克力时,优先挑选其他大品牌的巧克力产品若钟情费列罗巧克力,需仔细查看生产地,避开比利时阿尔隆工厂生产的产品,可选择国内生产或除比利时外;美国在新冠疫情全球最严重的背景下,近期又出现了沙门氏菌感染疫情,具体情况如下疫情波及范围美国疾病控制与预防中心CDC正在调查的沙门氏菌感染事件已波及23个州,显示出疫情扩散范围较广确诊人数与死亡情况截至目前,已有212人被确诊感染沙门氏菌,但尚未出现死亡病例这一数据表明,尽管疫。
4、2023年8月奥地利暴发三起沙门氏菌疫情,共27人患病1人死亡,疫情源头指向来自波兰的鸡肉以下是详细信息疫情概况据美国食品安全新闻网及食品伙伴网报道,2023年8月奥地利暴发三起沙门氏菌感染事件,累计报告病例27例,其中1人死亡此次疫情引发奥地利卫生和食品安全局卫生部及相关省级主管部门的联合;美国卫生部门和疾病控制和预防中心密切关注疫情发展联邦食品和药物管理局参与调查并协调召回行动官员警告称,沙门氏菌疫情可能比报告更严重,因为大多数沙门氏菌患者并未就医事件结果通过大规模召回行动,有效遏制了疫情的进一步蔓延强化了公众对食品安全问题的关注和意识促使相关部门加强对食品生产;事件起因2024年4月8日,意大利巧克力生产商费列罗宣布暂时关闭其比利时埃尔隆工厂,原因是该工厂生产的“健达惊喜蛋”Kinder Surprise被欧洲疾控中心ECDC调查发现与134例儿童沙门氏菌感染病例存在关联这些病例主要分布在欧洲多国,感染源指向工厂生产环节中的原料或环境污染中国市场涉事产品未;2025年6月美国爆发鸡蛋与黄瓜沙门氏菌污染事件,导致多州民众感染,暴露出食品安全监管与企业责任问题事件概述时间与机构2025年6月7日,美国疾控中心CDC和食品药品监督管理局FDA紧急应对两起食品安全事件事件类型鸡蛋召回170万枚鸡蛋因沙门氏菌污染被召回黄瓜疫情沙门氏菌污染黄瓜蔓延至18个州。

5、污染沙门氏菌的比利时巧克力已销往中国,目前全球启动召回,暂无死亡报告以下是详细信息疫情起源与通报当地时间3月27日,英国向世界卫生组织WHO通报了单相鼠伤寒沙门氏菌序列34型感染的聚集性病例调查显示,此次疫情与比利时生产的巧克力产品相关,这些巧克力已销往至少113个国家和地区,中国在受;春季是各种病毒爆发的季节,所以想要预防沙门氏菌那就要做到勤洗手,不吃生的食物因为这两点是沙门氏菌主要的传播途径,所以需要重点注意什么是沙门氏菌沙门氏菌是疾病预防和控制中常见的食物病原体,在全年食物中毒源中排名第一沙门氏菌可在粪便中存活12个月,在自然条件下可在冰箱中存活。
本文由金钢号于2026-03-25发表在金钢号,如有疑问,请联系我们。
本文链接:http://restaurantenna.com/post/27599.html
发表评论